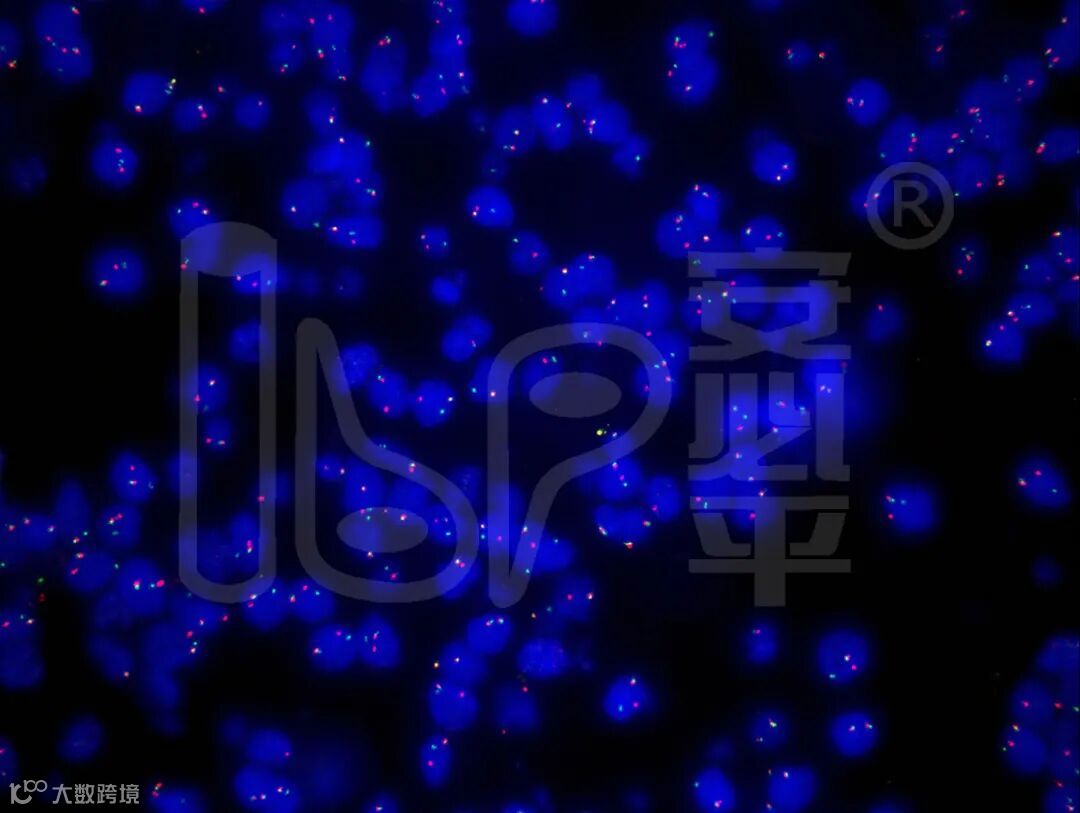
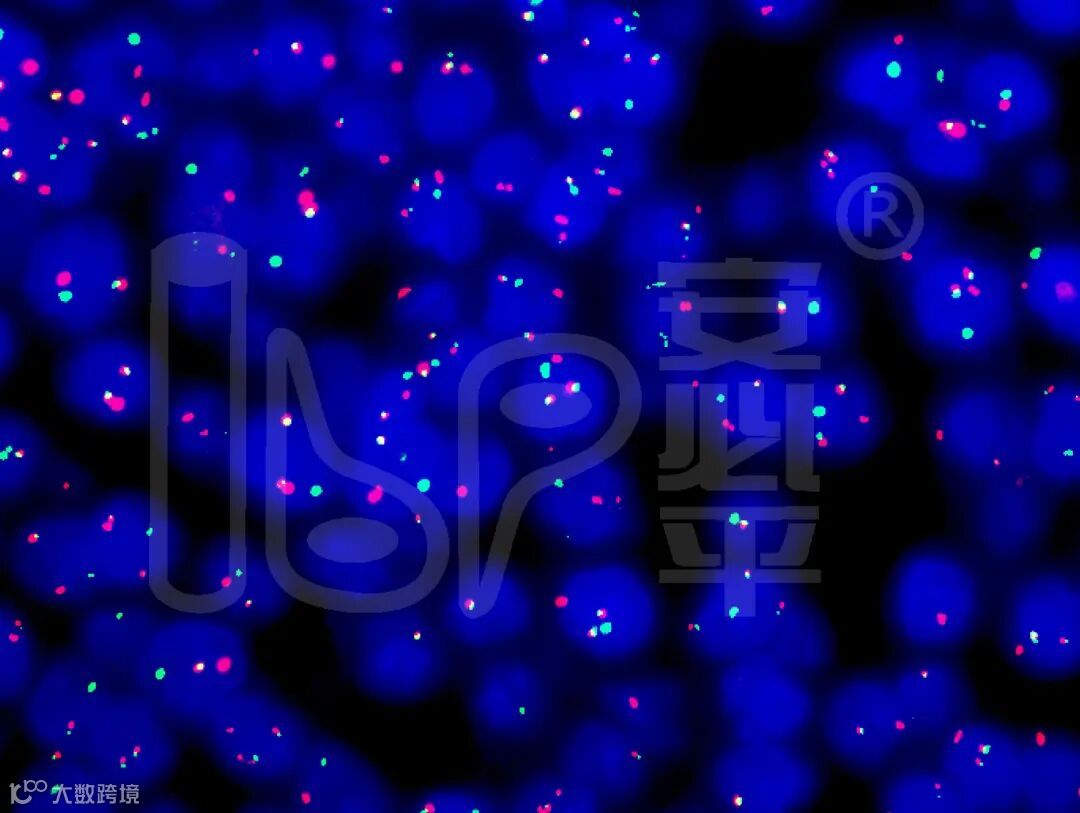

2021年9月11日淋巴造血系统疾病学组年会以线上形式呈现。卫星会环节,安必平邀请了空军军医大学西京医院的王哲教授带来专题讲座《FISH在淋巴瘤诊断中的应用》。王哲教授从淋巴瘤分类、病理诊断以及相应的分子异常介绍了FISH在淋巴瘤中的应用,最后结合病例对淋巴瘤整体诊断思路进行梳理,为大家带来了一场生动的学术分享。
淋巴瘤是中国常见的恶性肿瘤之一。2020年中国新发霍奇金淋巴瘤6829例,死亡2807例;新发非霍奇金淋巴瘤92834例,死亡54351例。淋巴瘤病理类型复杂,异质性强,治疗原则各有不同。近年来,随着人们对淋巴瘤本质认识的不断深入,淋巴瘤在诊断和治疗方面出现了很多新的研究结果,患者生存得到了改善。淋巴瘤中经常发生一些染色体的畸变,如断裂、融合,导致基因表达异常;而这些异常可以使用荧光原位杂交技术(FISH)进行检测。淋巴瘤中重现性的细胞遗传学异常很多,其中大部分可以用来辅助淋巴瘤诊断(表1)。如MYC-IGH融合基因常发生在伯基特淋巴瘤,BCL2-IGH融合常发生在滤泡性淋巴瘤。慢性淋巴细胞白血病/小淋巴细胞淋巴瘤中常出现13q缺失(约55%)、11q缺失(12%-18%)、17p缺失(5%-10%);其中11q和17p缺失与ATM、TP53基因缺失和功能失去有关。还会出现获得性的异常,如12号染色体三体(约15%);这些变异与临床的特征非常密切,可使用FISH方法来判断预后。预后差的比较为del(17p)>del(11q)>trisomy12>正常FISH结果>isolated del(13q)。MAF-IGH、FGFR3-IGH融合探针应用在多发性骨髓瘤中较多。
表1 淋巴瘤常见的细胞遗传学异常

讲座中还从探针类型进行了介绍,并进行案例分享。
分离探针的设计将异常基因断裂位点两端分别标记为红色和绿色,若基因未发生断裂重排,则表现为两个融合信号(阴性);若基因发生断裂重排,则表现为一红一绿一融合(典型阳性信号)。王哲教授介绍可以使用三通滤镜观察细胞核内出现的单色信号(红色/绿色),判断是否产生信号分离。淋巴瘤中常用的分离探针包括MYC、BCL2、BCL6、CCND1断裂探针,主要用于诊断Burkitt淋巴瘤,双打击淋巴瘤和套细胞淋巴瘤;其中BCL2断裂探针可用于辅助诊断滤泡性淋巴瘤。

Burkitt淋巴瘤的病理诊断思路
病例1
男性,63岁右颈部淋巴结肿大,HE形态以一致的中等大小的细胞为主,并非典型的弥漫大B细胞淋巴瘤,核分裂多,有一定异形。初步判断为不典型Burkitt淋巴瘤以及不典型弥漫大B细胞淋巴瘤。免疫组化表现CD20(+)、CD10(+),判断为生发中心来源的,BCL6(-)、MUM1(-)、Ki67(+)、BCL2(强阳)、MYC阳性(>70%)。
王哲教授提示,虽然以上指标也有一些在Burkitt淋巴瘤中表达,但是综合来看并不是Burkitt淋巴瘤,更像是双打击的弥漫大B细胞淋巴瘤。使用FISH探针检测后发现,MYC断裂探针为阳性,BCL2断裂探针为阳性;由此整体诊断为双打击淋巴瘤。诊断为高级别B细胞淋巴瘤,伴有MYC、BCL2基因重排。
双打击大B细胞淋巴瘤最初在Burkitt淋巴瘤中发现,常见MYC、BCL2、BCL6基因易位,其中MYC+BCL2 DH常表现为GCB表型,MYC+BCL6 DH常为ABC表型,若MYC+BCL2+BCL6则为三打击淋巴瘤,是预后差的表现。而该类淋巴瘤还可发生于TdT+B淋巴母细胞瘤(偶见)、浆母细胞淋巴瘤(罕见)、低级别滤泡性淋巴瘤(罕见),都与预后差相关。如果MYC的转位配对基因为免疫球蛋白(如IGH、IGK、IGL等),也是提示预后差的表现。
病例2
间变型弥漫大B细胞淋巴瘤
病例形态特征为弥漫出现间变细胞/在弥漫大B的背景下出现至少10%的间变细胞。免疫组化与FISH表现见图1。其中细胞遗传学表现除了经典的断裂以外,还会出现MYC/BCL2/BCL6的基因多拷贝。王哲教授提示大家注意,在分离探针的应用中,不仅要关注断裂,对于基因的多拷贝状态也是关注的重点。文献资料中对于非典型的DH-DLBCL的一种新观点:MYC与BCL2/BCL6同时出现多拷贝(大于4 copies/cell),P53免疫组化阳性(>50%),同时MYC基因断裂,提示预后和治疗反应较差。

图1 间变型弥漫大B细胞淋巴瘤
病例3
样本形态特征表现为大的紧密排列的膨胀性滤泡,主要由中心母细胞和中等大的母细胞组成,圆形或者卵圆形细胞核,染色质为细颗粒状,核仁小,胞浆少,有时可出现星空现象。免疫组化和FISH表现:MUM1(+)、BCL2(+)(63%)、CD10(+)、BCL6(+)。分子检测发现,无BCL2/IGH基因转位,有IRF4基因断裂。以上表现也可能发生于IRF4转位的大B细胞淋巴瘤,预后都很好。诊断为咽淋巴环儿童型DLBCL。
由于IRF4断裂探针的设计上DUSP22与IRF4两个基因挨得很近,故DUSP22基因异常也可以使用IRF4断裂探针来检测,可应用在ALK阴性的间变大细胞淋巴瘤,该类淋巴瘤也会伴有TP63重排(8%),该重排预后最差。
融合探针是基于已知融合基因来设计的,将融合伙伴基因分别标记为红色和绿色,若两个基因未发生融合,则表现两对分离的红绿信号(阴性);若两个基因发生融合,则表现为一红一绿两融合(典型阳性信号)。融合基因存在的线索:不仅有信号融合而且有每个核信号数量的增加。
【融合与分离探针的对比】
优点:能识别融合的两个基因,能识别罕见的癌基因近端有小插入的病例(分离探针可能会漏掉)
缺点:不如分离探针用途广;由于信号数量多,切片信号截断导致判读困难。
病例4
患者为男性,34岁,左锁骨上淋巴结肿大1月。形态特征:结节状病灶,主要以大细胞为主,散在小细胞。免疫组化:CD20(弥漫阳性)、CD3(少阳)、Ki67(+)、BCL6(+)、CD10(-)、CD21((+)、MUM1(-)、BCL2(+)以上支持滤泡性淋巴瘤,Cyclin D1(生发中心很多小细胞阳性)、CD5(散在阳性)、CD43(+)。临床诊断时认为可能是滤泡性淋巴瘤?或套细胞淋巴瘤?使用FISH探针进行补充检测,发现CCNG1-IGH融合(-),BCL2-IGH融合(-)。双染:BCL-2+Cyclin D1(+)。最终诊断:复合性套细胞淋巴瘤/滤泡性淋巴瘤IIIb,伴有混合特征。
患者经过5周期CHOP治疗,PR;8个月后死于脑膜受累;可见预后很差。
值得注意的是在融合探针中也会出现单信号小簇以及多拷贝数增加。
病例5
患者为女性,背部疼痛逐渐加重2月,双下肢瘫痪10天,CT显示11th-12th胸椎占位,椎骨破坏。形态特征:大量典型浆细胞弥漫分布,细胞大,出现大量红色结晶;免疫组化:CD138(+)、CD38(弱阳)、MUM-1(+)、Ki67(+)、Lamda(+)、Kappa(-)。以上诊断为浆细胞瘤伴有Crystalstoring histiocytosis(晶体储积性组织细胞增多症)。使用FISH探针检测FGFR3-IGH融合(+)。最终诊断:高级别浆细胞瘤伴有IGH-FGFR3融合,同时有晶体储积性组织细胞增多症,预后差。
专题最后的总结中,王教授强调,FISH技术通过对细胞遗传学异常的检测,在淋巴瘤的诊断,预后的判断、特殊类型的发现有很大的帮助。
以上卫星会提到的探针类型以及效果图如下:


左:BCL2-IGH 右:BLC2拷贝数增加


左:BCL2阳性 右:CCND1-IGH

左:MYC阳性 右:MYC-IGH


左:IRF4 右:FGFR3-IGH
淋巴瘤探针的应用情况

点击下方阅读原文可查看探针详情
—END—



